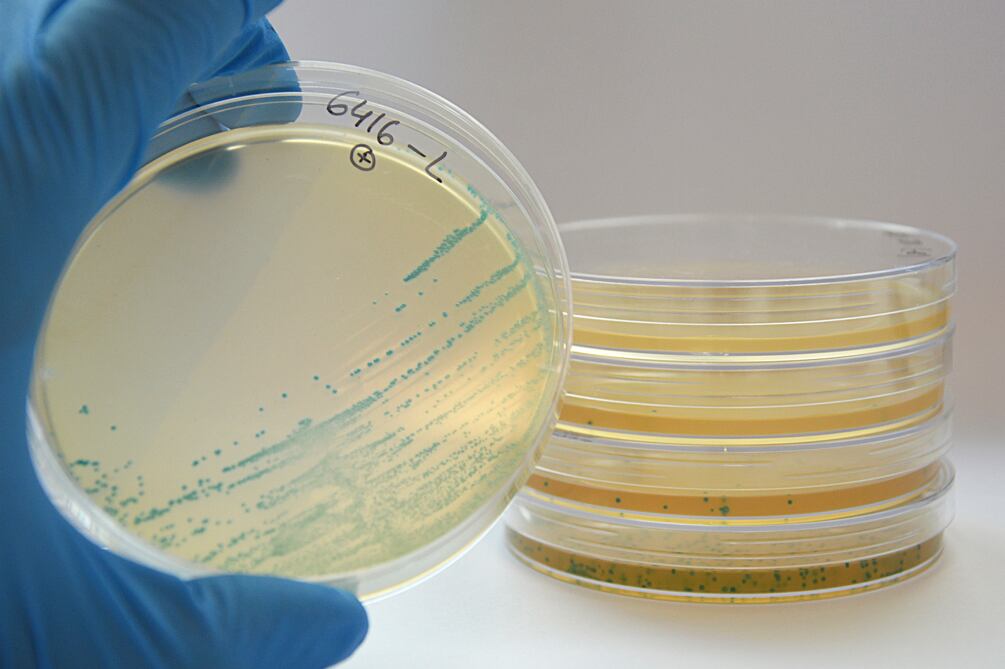

Más de 400 productos alimenticios vendidos bajo docenas de marcas fueron retirados del mercado debido a una posible contaminación con Listeria, anunció la Administración de Drogas y Alimentos de Estados Unidos.
PUBLICIDAD
El retiro del mercado de Fresh Ideation Food Group LLC incluye sándwiches, ensaladas, yogures, wraps y otros productos listos para comer vendidos en nueve estados y Washington, DC, del 24 al 30 de enero.
Enfermedades
La compañía de Baltimore dijo que hasta el momento no se han reportado enfermedades.
“El retiro se inició después de que las muestras ambientales de la compañía dieron positivo para Listeria monocytogenes”, dijo Fresh Ideation Food Group en su anuncio de retiro.
Alimentos con Listeria
Comer alimentos contaminados con Listeria puede causar una infección grave que puede provocar síntomas como fiebre, dolor de cabeza, diarrea y vómitos, según los Centros para el Control y la Prevención de Enfermedades de Estados Unidos.
Es más probable que enferme a mujeres embarazadas y sus recién nacidos, adultos mayores de 65 años y personas con sistemas inmunitarios debilitados, según los CDC. “Se estima que 1.600 personas contraen listeriosis cada año y unas 260 mueren”, dice la agencia.
Alimentos retirados
Los alimentos retirados se distribuyeron en Connecticut, el Distrito de Columbia, Maryland, Massachusetts, Nueva Jersey, Nueva York, Carolina del Norte, Pensilvania, Carolina del Sur y Virginia, según la FDA.
PUBLICIDAD
Los productos, que incluían artículos como muffins de tocino, huevo y queso cheddar, croissants de desayuno, sándwiches de atún y pollo, y tazas de frutas, se vendieron en tiendas, máquinas expendedoras y proveedores de transporte, según la compañía.
“Todos los productos retirados tienen una etiqueta y/o identificador de Fresh Creative Cuisine en la parte inferior de la etiqueta con el nombre de Fresh Creative Cuisine y una fecha de vencimiento o de venta que va desde el 31 de enero de 2023 hasta el 6 de febrero de 2023″, dijo la compañía.